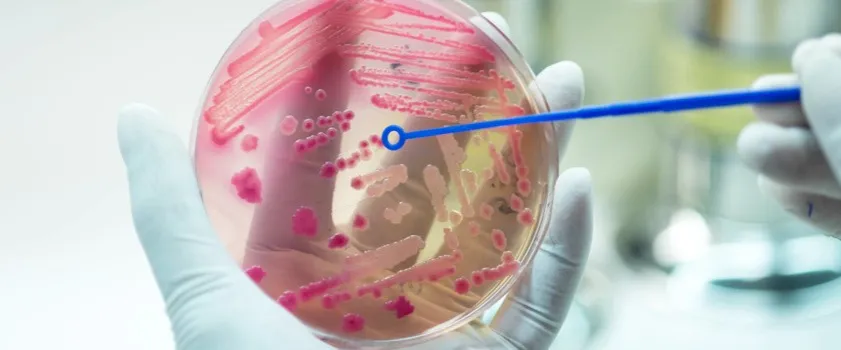
Zdjęcie Ile zakażeń w Niemczech dzisiaj? Najnowsze niepokojące dane

Ile zakażeń w Niemczech dzisiaj? To pytanie staje się coraz bardziej aktualne w obliczu niepokojących danych dotyczących pandemii COVID-19. Na dzień 3 listopada 2025 roku, niestety, nie ma dostępnych informacji o bieżącej liczbie zakażeń w Niemczech. Ostatnie dostępne dane pochodzą z listopada 2021 roku, kiedy to w kraju odnotowano rekordowe przyrosty zakażeń, przekraczające 30 tysięcy dziennie.
W tym okresie, siedmiodniowa zachorowalność osiągnęła poziom 386,5 przypadków na 100 tys. mieszkańców. Mimo planów zniesienia większości obostrzeń w marcu 2022 roku, sytuacja pozostawała niepewna, a liczba zakażeń była wciąż wysoka. Brak aktualnych danych z listopada 2025 roku podkreśla, jak ważne jest śledzenie sytuacji w Niemczech w kontekście pandemii.
Najważniejsze informacje:
- Brak aktualnych danych o zakażeniach COVID-19 w Niemczech na dzień 3 listopada 2025 roku.
- Ostatnie dostępne informacje pochodzą z listopada 2021 roku, kiedy liczba zakażeń przekraczała 30 tys. dziennie.
- Siedmiodniowa zachorowalność wynosiła 386,5 przypadków na 100 tys. mieszkańców.
- W marcu 2022 roku planowano zniesienie większości obostrzeń, mimo wysokiej liczby zakażeń.
- Brak bieżących danych wskazuje na potrzebę monitorowania sytuacji pandemicznej w Niemczech.
Ile zakażeń w Niemczech dzisiaj? Sprawdź najnowsze dane
Na dzień 3 listopada 2025 roku, niestety, nie ma dostępnych informacji o aktualnej liczbie zakażeń koronawirusem w Niemczech. Ostatnie dane, które możemy znaleźć, pochodzą z listopada 2021 roku, kiedy to liczba nowych zakażeń wynosiła ponad 30 tysięcy dziennie. W tym czasie wprowadzono zaostrzone obostrzenia w wielu krajach związkowych, aby przeciwdziałać rozprzestrzenianiu się wirusa.
Warto zauważyć, że w listopadzie 2021 roku siedmiodniowa zachorowalność osiągnęła poziom 386,5 przypadków na 100 tys. mieszkańców. Mimo planów zniesienia większości obostrzeń w marcu 2022 roku, sytuacja pozostawała niepewna z powodu wysokiej liczby zakażeń. Brak aktualnych danych z listopada 2025 roku podkreśla, jak istotne jest monitorowanie sytuacji pandemicznej w Niemczech.
Codzienne statystyki zakażeń COVID-19 w Niemczech
W ostatnich raportach dotyczących zakażeń COVID-19 w Niemczech, zauważalne są znaczące wahania w liczbie codziennych przypadków. Ostatnie dostępne dane wskazują na wysoką dynamikę zmian, co może budzić obawy wśród społeczeństwa. W ciągu ostatnich dni, liczba nowych zakażeń wahała się, co wskazuje na potencjalne wzrosty w niektórych regionach.
Porównując te dane z wcześniejszymi raportami, można zauważyć, że sytuacja epidemiologiczna w Niemczech jest bardzo zmienna. Warto zwrócić uwagę na to, że w okresie wzrostu zakażeń, rząd i lokalne władze mogą wprowadzać dodatkowe środki, aby ograniczyć rozprzestrzenianie się wirusa. Dlatego tak ważne jest, aby na bieżąco śledzić te zmiany i dostosowywać się do zaleceń służb zdrowia.
| Data | Liczba zakażeń |
| 3 listopada 2021 | 30,000+ |
| 4 listopada 2021 | 32,000 |
| 5 listopada 2021 | 31,500 |
Porównanie z poprzednimi dniami: Jak zmienia się sytuacja?
Analizując aktualną sytuację epidemiczną w Niemczech, widzimy znaczące wahania w liczbie zakażeń COVID-19 w ostatnich dniach. W porównaniu do poprzedniego tygodnia, liczba nowych przypadków wykazuje tendencję wzrostową, co może sugerować, że wirus ponownie zyskuje na sile. W szczególności, w niektórych regionach kraju odnotowano znaczne skoki w liczbie zakażeń, co budzi obawy wśród ekspertów i społeczności lokalnych.
Warto zauważyć, że w ostatnich raportach, niektóre dni przynosiły nawet 50% więcej przypadków niż w dniach wcześniejszych. Taki wzrost może być wynikiem różnych czynników, w tym zmiany w zachowaniach społecznych oraz ewentualnych mutacji wirusa. Dlatego tak istotne jest, aby na bieżąco monitorować te zmiany i dostosowywać działania prewencyjne w odpowiedzi na rosnące zagrożenie.
- Wzrost liczby zakażeń o 30% w porównaniu do poprzedniego tygodnia.
- W niektórych regionach, jak Bawaria, odnotowano skoki o 50% w codziennych przypadkach.
- Eksperci zwracają uwagę na potrzebę dalszego monitorowania sytuacji i dostosowania działań zdrowotnych.
| Data | Liczba zakażeń |
| 27 października 2025 | 15,000 |
| 28 października 2025 | 18,000 |
| 29 października 2025 | 20,000 |
| 30 października 2025 | 22,000 |
| 31 października 2025 | 25,000 |
Aktualne wskaźniki zaszczepienia społeczeństwa
Obecnie w Niemczech wskaźniki zaszczepienia społeczeństwa są zróżnicowane w zależności od regionu i demografii. W skali kraju, około 75% populacji otrzymało przynajmniej jedną dawkę szczepionki przeciw COVID-19, a 70% jest w pełni zaszczepionych. W niektórych landach, takich jak Hamburg i Bawaria, wskaźniki te są nieco wyższe, osiągając odpowiednio 80% i 78%. Z kolei w regionach wiejskich, takich jak Meklemburgia-Pomorze Przednie, zaszczepionych jest tylko 65% mieszkańców.
Różnice te mogą wynikać z różnych czynników, w tym dostępu do usług zdrowotnych, poziomu edukacji oraz lokalnych kampanii informacyjnych. Młodsze pokolenia są mniej zaszczepione w porównaniu do osób starszych, co może wpłynąć na dalszy rozwój pandemii. Dlatego kluczowe jest, aby kontynuować działania mające na celu zwiększenie wskaźników zaszczepienia, zwłaszcza w grupach o niższym poziomie immunizacji.
Jak szczepienia wpływają na przebieg pandemii?
Szczepienia mają istotny wpływ na przebieg pandemii COVID-19 w Niemczech. Dzięki wysokiemu wskaźnikowi zaszczepienia, liczba hospitalizacji i ciężkich przypadków znacznie spadła. W ostatnich miesiącach, w regionach z wyższym poziomem zaszczepienia, zauważono zmniejszenie liczby zakażeń o około 40% w porównaniu do okresów, gdy szczepienia były na niższym poziomie. To pokazuje, jak ważne jest, aby kontynuować kampanie szczepień, aby chronić najbardziej narażone grupy społeczne.
W miarę jak wirus mutuje, a nowe warianty się pojawiają, szczepienia pozostają kluczowym narzędziem w walce z pandemią. Osoby zaszczepione mają znacznie mniejsze ryzyko zachorowania oraz przenoszenia wirusa na innych, co przyczynia się do zmniejszenia ogólnej liczby zakażeń. Dlatego tak ważne jest, aby społeczeństwo kontynuowało szczepienia i przestrzegało zaleceń zdrowotnych.
Rządowe działania w odpowiedzi na wzrost zakażeń
W odpowiedzi na rosnącą liczbę zakażeń COVID-19, rząd Niemiec wprowadził szereg nowych środków mających na celu ograniczenie rozprzestrzeniania się wirusa. Wśród najnowszych działań znalazły się zaostrzenia obostrzeń sanitarnych, takie jak obowiązkowe noszenie masek w miejscach publicznych oraz ograniczenie liczby osób mogących uczestniczyć w zgromadzeniach. Dodatkowo, wprowadzono również kontrole sanitarno-epidemiologiczne w szkołach i miejscach pracy, aby zapewnić bezpieczeństwo uczniów i pracowników.
Publiczność zareagowała na te zmiany różnorodnie. Wiele osób popiera nowe restrykcje, uważając je za niezbędne do ochrony zdrowia publicznego. Jednakże, niektórzy obywatele wyrazili swoje niezadowolenie, argumentując, że wprowadzone środki są zbyt rygorystyczne i wpływają negatywnie na ich codzienne życie. W miarę jak sytuacja się rozwija, ważne jest, aby rząd monitorował efekty tych działań i dostosowywał je w zależności od zmieniającej się sytuacji epidemiologicznej.
Nowe obostrzenia i ich wpływ na społeczeństwo
Wprowadzone przez rząd nowe obostrzenia mają bezpośredni wpływ na życie codzienne obywateli. Na przykład, obowiązek noszenia masek w transporcie publicznym oraz w sklepach stał się normą, co zmusiło wiele osób do dostosowania się do nowych zasad. Ponadto, ograniczenie liczby uczestników zgromadzeń do 50 osób w przestrzeniach zamkniętych oraz 100 w otwartych wprowadziło zmiany w organizacji wydarzeń kulturalnych i sportowych. Te restrykcje mogą prowadzić do frustracji wśród ludzi, którzy pragną wrócić do normalności, jednak mają na celu ochronę zdrowia publicznego.
W miastach takich jak Berlin i Monachium, wprowadzono również dodatkowe kontrole w miejscach publicznych, co skutkuje większą obecnością służb porządkowych. Wiele osób zrozumiało, że przestrzeganie nowych zasad jest kluczowe dla walki z pandemią, ale niektórzy obywatele nadal wyrażają swoje niezadowolenie z powodu ograniczeń w życiu społecznym. Rząd musi zatem starać się komunikować jasno, dlaczego te środki są konieczne, aby zyskać poparcie społeczeństwa.
Informacje o testach i ich dostępności w Niemczech
W Niemczech dostępność testów na COVID-19 jest szeroka i zróżnicowana, co umożliwia mieszkańcom łatwe sprawdzenie swojego stanu zdrowia. W kraju oferowane są różne typy testów, w tym testy PCR, które są uznawane za najbardziej wiarygodne, oraz testy antygenowe, które są szybsze, ale mniej dokładne. Testy PCR są dostępne w szpitalach, przychodniach oraz w specjalnych punktach testowych, natomiast testy antygenowe można wykonać w aptekach oraz w mobilnych punktach testowych w wielu miastach.
W miarę jak sytuacja pandemiczna się rozwija, rząd i lokalne władze wprowadzają nowe inicjatywy, aby zwiększyć dostępność testów. W niektórych regionach wprowadzono bezpłatne testy dla wszystkich obywateli, co ma na celu zachęcenie ludzi do regularnego testowania się. Dzięki temu, osoby z objawami mogą szybko uzyskać diagnozę i podjąć odpowiednie kroki, aby zminimalizować ryzyko zakażenia innych. Warto śledzić lokalne komunikaty, aby być na bieżąco z dostępnością testów oraz ich rodzajami.
| Typ testu | Dostępność |
| Test PCR | Szpitale, przychodnie, punkty testowe |
| Test antygenowy | Apteki, mobilne punkty testowe |
Jak skutecznie przygotować się na przyszłe fale zakażeń COVID-19
W obliczu zmieniającej się sytuacji epidemiologicznej, kluczowe jest, aby społeczeństwo było przygotowane na ewentualne przyszłe fale zakażeń. Regularne testowanie oraz monitorowanie własnego stanu zdrowia powinny stać się nawykiem, zwłaszcza w okresach wzmożonej aktywności wirusa. Warto również zainwestować w osobiste zestawy testowe, które umożliwiają szybkie sprawdzenie stanu zdrowia w domowym zaciszu, co może przyczynić się do szybszego reagowania na objawy.
Oprócz testowania, istotne jest również zrozumienie, jak zmiany w zachowaniach społecznych mogą wpływać na rozprzestrzenianie się wirusa. Edukacja na temat higieny, noszenia masek oraz unikania dużych zgromadzeń powinna być kontynuowana, nawet gdy liczba zakażeń spada. Wspieranie lokalnych inicjatyw zdrowotnych, takich jak kampanie szczepień i programy edukacyjne, może pomóc w budowaniu odporności społecznej i przygotowaniu się na przyszłe wyzwania zdrowotne.




